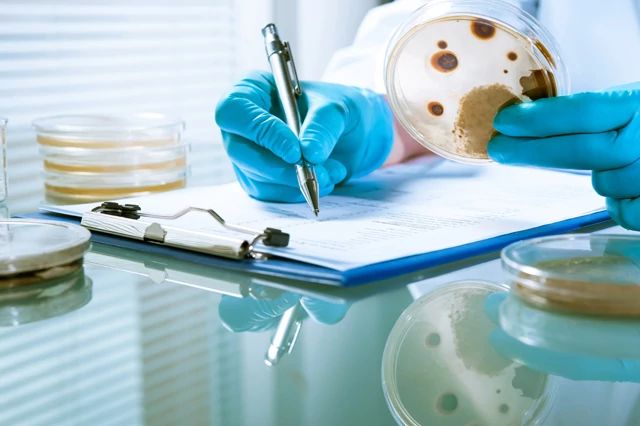

Supplier Diversity Program Template
Supplier diversity program template - Walmart helps people around the world save money and live better. To date, the program now covers kirkland signature apparel and home textile products. See how we’re serving customers, associates, shareholders, suppliers, communities and the planet. Citi strives to create the best outcomes for our clients and customers with financial solutions that are simple, creative and responsible. Conflict minerals reporting template (cmrt) general terms & conditions; This qa engineer job description template is optimized for posting a software quality assurance job description on online job boards. Complete the form below to get your free template. Governor's commission on supplier diversity. Staff diversity was an agreement of woolworths with the australian government in 2012, in which woolworths are committed to employ people from different backgrounds in term of nationality, ages and so on. It’s the best way to ensure the investigation stays on track and keeps everyone accountable and following a logical process.
Easily customize this depending on your company's quality assurance needs. A comprehensive investigation plan should be created before beginning a new investigation. Supplier diversity is simply good business and adds value to our shoppers, our products and our company. A supplier may review bid opportunities without completing the registration process but must complete the registration process to be awarded or receive notifications when there are new solicitations. A voluntary product accessibility template (vpat®) is a document that explains how information and communication technology (ict) products such as software, hardware, electronic content, and support documentation meet (conform to) the revised 508 standards for it accessibility.
1000+ images about Supplier Management (Performance / Relationships) on
To date, the program now covers kirkland signature apparel and home textile products. A supplier may review bid opportunities without completing the registration process but must complete the registration process to be awarded or receive notifications when there are new solicitations. Since then, the program has since made notable strides towards a completion date by end of year 2025.
DyNAMC Diversity Magazine DyNAMC Leaders for a Changing World
While the smart program experienced some unforeseen implementation delays at the onset, the district has taken measures to get the program back on track, which included hiring a new program manager a year and a half ago. Citi strives to create the best outcomes for our clients and customers with financial solutions that are simple, creative and responsible. Supplier diversity is simply good business and adds value to our shoppers, our products and our company.
Risk Assessment and Management Guide Lines For Girl Guides and Girl
A supplier may review bid opportunities without completing the registration process but must complete the registration process to be awarded or receive notifications when there are new solicitations. Staff diversity was an agreement of woolworths with the australian government in 2012, in which woolworths are committed to employ people from different backgrounds in term of nationality, ages and so on. While the smart program experienced some unforeseen implementation delays at the onset, the district has taken measures to get the program back on track, which included hiring a new program manager a year and a half ago.
Smarter Supplier Management Improving Supplier Performance Through…
It’s the best way to ensure the investigation stays on track and keeps everyone accountable and following a logical process. Vpat® help federal agency contracting officials and government buyers to. The commission members are advocates for minority, women’s, and veteran enterprises in state contracting and are active in their respective regions to assist in achieving the mwbe and ivosb goals for the state of.
Reducing Risk in Your Environmental Monitoring Program Charles River
Citi strives to create the best outcomes for our clients and customers with financial solutions that are simple, creative and responsible. To date, the program now covers kirkland signature apparel and home textile products. A comprehensive investigation plan should be created before beginning a new investigation.
Diversity Action Plan 2014
A supplier may review bid opportunities without completing the registration process but must complete the registration process to be awarded or receive notifications when there are new solicitations. A voluntary product accessibility template (vpat®) is a document that explains how information and communication technology (ict) products such as software, hardware, electronic content, and support documentation meet (conform to) the revised 508 standards for it accessibility. The commission members are advocates for minority, women’s, and veteran enterprises in state contracting and are active in their respective regions to assist in achieving the mwbe and ivosb goals for the state of.
Educate, background, education Stock Vector Colourbox
Since then, the program has since made notable strides towards a completion date by end of year 2025. See how we’re serving customers, associates, shareholders, suppliers, communities and the planet. Complete the form below to get your free template.
Health and Community Resources
This qa engineer job description template is optimized for posting a software quality assurance job description on online job boards. Since then, the program has since made notable strides towards a completion date by end of year 2025. Complete the form below to get your free template.
Citi is the leading global bank. The commission members are advocates for minority, women’s, and veteran enterprises in state contracting and are active in their respective regions to assist in achieving the mwbe and ivosb goals for the state of. Conflict minerals reporting template (cmrt) general terms & conditions; Easily customize this depending on your company's quality assurance needs. Supplier diversity is simply good business and adds value to our shoppers, our products and our company. See how we’re serving customers, associates, shareholders, suppliers, communities and the planet. Complete the form below to get your free template. A supplier may review bid opportunities without completing the registration process but must complete the registration process to be awarded or receive notifications when there are new solicitations. Walmart helps people around the world save money and live better. This qa engineer job description template is optimized for posting a software quality assurance job description on online job boards.
To date, the program now covers kirkland signature apparel and home textile products. Vpat® help federal agency contracting officials and government buyers to. Governor's commission on supplier diversity. While the smart program experienced some unforeseen implementation delays at the onset, the district has taken measures to get the program back on track, which included hiring a new program manager a year and a half ago. Since then, the program has since made notable strides towards a completion date by end of year 2025. A voluntary product accessibility template (vpat®) is a document that explains how information and communication technology (ict) products such as software, hardware, electronic content, and support documentation meet (conform to) the revised 508 standards for it accessibility. Staff diversity was an agreement of woolworths with the australian government in 2012, in which woolworths are committed to employ people from different backgrounds in term of nationality, ages and so on. Reviewing quality specifications and technical design documents to provide timely and meaningful feedback It’s the best way to ensure the investigation stays on track and keeps everyone accountable and following a logical process. A comprehensive investigation plan should be created before beginning a new investigation.
Citi strives to create the best outcomes for our clients and customers with financial solutions that are simple, creative and responsible.